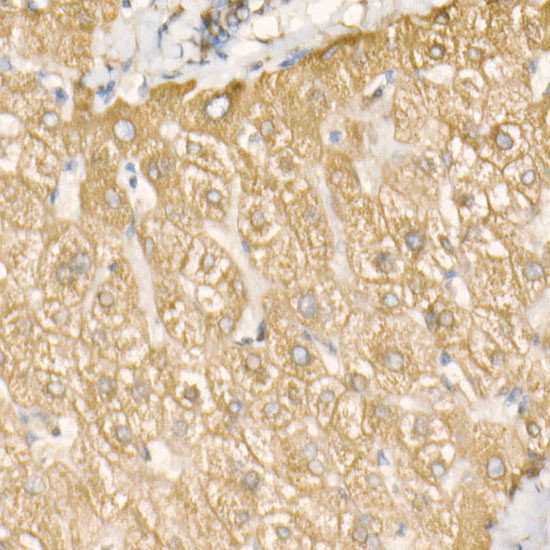
GRP78 Antibody in Immunohistochemistry (Paraffin) (IHC (P))

Search
Invitrogen
GRP78 Recombinant Rabbit Monoclonal Antibody (2O7F4)
{{$productOrderCtrl.translations['antibody.pdp.commerceCard.promotion.promotions']}}
{{$productOrderCtrl.translations['antibody.pdp.commerceCard.promotion.viewpromo']}}
{{$productOrderCtrl.translations['antibody.pdp.commerceCard.promotion.promocode']}}: {{promo.promoCode}} {{promo.promoTitle}} {{promo.promoDescription}}. {{$productOrderCtrl.translations['antibody.pdp.commerceCard.promotion.learnmore']}}
图: 1 / 4
GRP78 Antibody (MA5-51510) in IHC (P)




Please note: We are reviewing Western blot images included in the antibody testing data in our catalog, including those provided by third parties. Unless expressly labeled or annotated as “raw-unedited”, Western blot images included in the antibody testing data in our catalog may have been edited, optimized or otherwise adjusted for presentation.
产品信息
MA5-51510
种属反应
宿主/亚型
Expression System
分类
类型
克隆号
抗原
偶联物
形式
浓度
规格
纯化类型
保存液
内含物
保存条件
运输条件
RRID
产品详细信息
Immunogen sequence: NRLTPEEIER MVNDAEKFAE EDKKLKERID TRNELESYAY SLKNQIGDKE KLGGKLSSED KETMEKAVEE KIEWLESHQD ADIEDFKAKK KELEEIVQPI
靶标信息
GRP78 is a 78 kDa glucose regulated protein that belongs to the family of heat shock proteins that include HSP70. GRP78 is a resident protein of the endoplasmic reticulum (ER) and associates transiently with a variety of newly synthesized secretory and membrane proteins. GRP78 may also interact with mutant and misfolded proteins, marking them for degradation. The highly conserved sequence Lys-Asp-Glu-Leu (KDEL) is present at the C-terminus of GRP78 and other resident ER proteins including glucose regulated protein 94 (GRP94) and protein disulfide isomerase (PDI). The KDEL signal is recognized by the KDEL receptor and this interaction ensures recycling of escaped ER proteins back to the ER. GRP78's involvement in correct folding of proteins and degradation of misfolded proteins is via its interaction with DNAJC10, probably to facilitate the release of DNAJC10 from its substrate. GRP78 is critical for maintenance of cell homeostasis and the prevention of apoptosis. GRP78 protein levels have been shown to be a reliable biomarker of hypoglycemia and serves a neuroprotective function in neurons exposed to glutamate and oxidative stress. GRP78 levels are reduced in the brains of Alzheimer's Disease patients, and decreased expression of GRP78 is found associated with missense mutations in the human presenilin-1 (PS1) gene. Further, the induction of the GRP78 protein has been associated with the development of drug-resistance to antitumor drugs.
仅用于科研。不用于诊断过程。未经明确授权不得转售。
篇参考文献 (0)
生物信息学
蛋白别名: 78 kDa glucose-regulated protein; Binding-immunoglobulin protein; BiP; Endoplasmic reticulum chaperone BiP; FLJ26106; glucose regulated protein, 78 kDa; GRP 78; GRP-78; heat shock 70 kDa protein 5; heat shock 70kD protein 5; heat shock 70kD protein 5 (glucose-regulated protein, 78kD); heat shock 70kDa protein 5 (glucose-regulated protein); Heat shock protein 70 family protein 5; Heat shock protein family A member 5; HSP70 family protein 5; HSPA 5; Immunoglobulin heavy chain-binding protein; Steroidogenesis-activator polypeptide; XAP-1 antigen
基因别名: AL022860; AU019543; baffled; BIP; D2Wsu141e; D2Wsu17e; GRP78; Hsce70; HSPA5; mBiP; SEZ-7; Sez7
UniProt ID: (Rat) P06761, (Mouse) P20029
Entrez Gene ID: (Rat) 25617, (Mouse) 14828